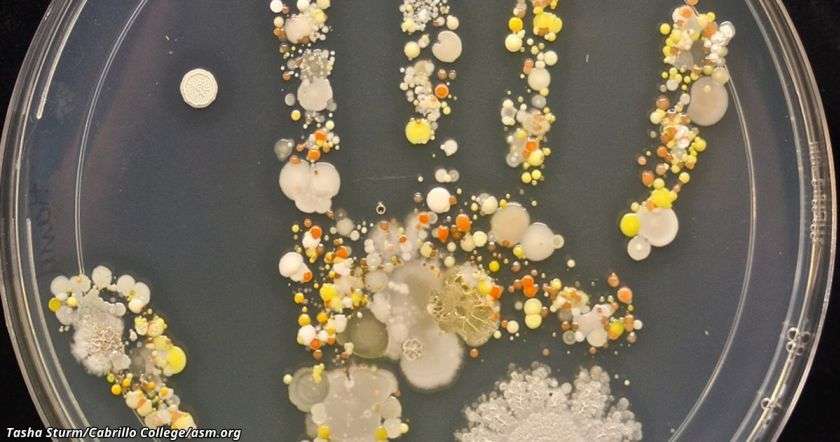

Таша Стурм, которая работала лаборанткой в микробиологической лаборатории колледжа Кабрилло в Аптосе, штат Калифорния, часто видела, как студенты берут микробные пробы для простых экспериментов с окружающих предметов типа дверных ручек и телефонов.
«В частности, это хороший способ показать, что микробы есть везде», — говорит она.
По словам Стурм, её двое детей с удовольствием проводят подобные опыты дома, а её сын особенно заинтересовался изучением своих рук.
«Он как прицепился ко мне: “Когда уже можно будет это сделать?”»
Весной 2015 года, когда он собирался в школу, Стурм попросила его поиграть во дворе и погладить семейную собаку. Когда мальчик вернулся, она ждала его с подготовленной агаровой пластинкой — стерильной чашкой Петри, наполненной веществом для выращивания бактерий.
Мальчик приложил руку к пластинке, после чего Стурм выдержала рассадник при температуре тела около суток и поместила в комнатную температуру.
Примерно через неделю она сделала снимок бактерий. И как же отреагировал её сын?
«Он сказал: “круто!”. А потом моя дочка сказала: “Давай теперь проверим собачий нос, давай лапу, давай кошачий хвост”», — вспоминает Стурм.
Стурм говорит, что большой белый круг внизу справа — это палочковидная бактерия, которая часто встречается в земле.
Другие белые пятна — возможно, стафилококки, а жёлтые и оранжевые — дрожжевой грибок.
«Это обычные бактерии, с которыми мы сталкиваемся каждый день. Кожа защищает нас от кучи всякой дряни, — говорит Стурм. — Главный вывод таков: чтобы иммунная система была здоровой, необходим постоянный контакт с микробами».
И действительно, «гигиеническая гипотеза» утверждает, что слишком чистая среда вызывает у детей повышенную реакцию на аллергены.
Оба ребёнка Стурм знают, что если они гладили собаку или играли во дворе, перед едой обязательно мыть руки. По её словам, это элементарные правила гигиены.










